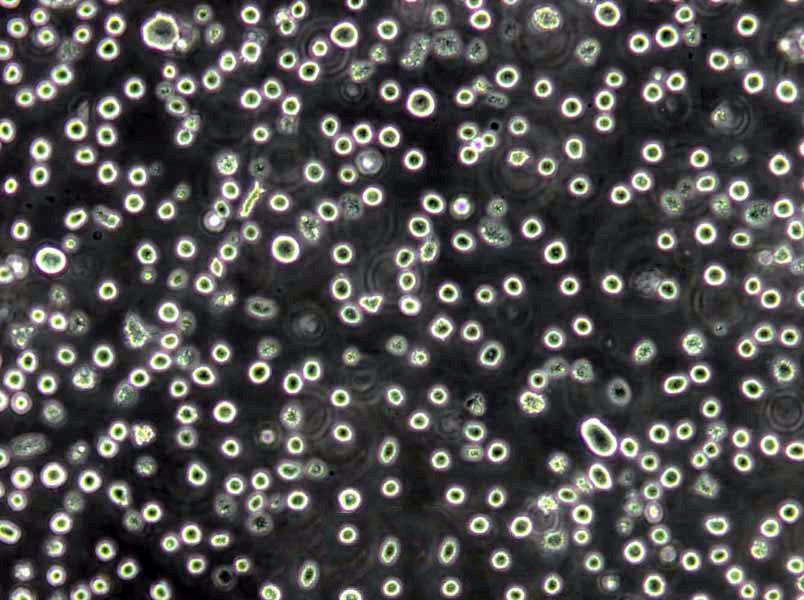
SHP-77 Cells(赠送Str鉴定报告)|人肺癌细胞

"SHP-77 Cells(赠送Str鉴定报告)|人肺癌细胞
细胞背景资料:详见相关文献介绍
细胞形态:上皮细胞样
传代培养及其操作步骤:原代细胞培养成功以后,需要进行分离培养,否则细胞会因生存空间不足或密度过大,营养障碍,影响细胞生长。细胞由原培养瓶内分离稀释后传到新的培养瓶中培养的过程称之为传代培养。传代细胞允许培养的细胞扩增(形成细胞株),可以进行细胞克隆,易于保存,但可能丧失一些殊的细胞和分化征。传代细胞形成细胞株的Zui大利处在于提供了大量持久的实验材料,便于实验。【操作步骤】1)吸掉或倒掉培养瓶内旧培养液;2)向瓶内加入胰蛋白酶液和EDTA混合液少量。以能覆盖培养瓶底为宜;3)置37℃孵箱或室温(25℃温度)下进行消化,2~5min后把培养瓶放在倒置显微镜下进行观察,当发现胞质回缩、细胞间隙增大后,应立即中止消化;4)吸出消化液,向瓶内加入Hanks液少量,轻轻转动培养瓶,把残留消化液冲掉,然后再加培养液。如果仅使用胰蛋白酶消化,在吸除胰蛋白液后,可直接加入少量含血清的培养液,终止消化;5)使用弯头吸管,吸取瓶内培养液,按顺序反复轻轻吹打瓶壁细胞,使之从瓶壁脱离形成细胞悬液。吹打时动作要轻柔,以防用力过猛损伤细胞;6)用计数板计数后,分别接种于新的培养瓶中,置CO2培养箱中进行培养;7)细胞培养换液时间应根据细胞生长的状态和实验要求来确定。一般2~3d后应换一次生长液。待细胞铺满器皿底面,即可使用;也可继续传代扩大培养或换成维持液。【注意事项】1)掌握HAO细胞消化的时间,消化时间过短时,细胞不宜从瓶壁脱落,过长的消化会导致细胞脱落、损伤;2)掌握HAO消化浓度,当消化液浓度过GAO时,消化时间应缩短,过低时细胞消化时间相对延长。
细胞生长:贴壁
EJ-1细胞类似产品::Functional Liver Cell-7细胞、FHCRC subclone 11细胞、Cor L88细胞
HCC1187细胞类似产品::ARIP细胞、BNL.CL2细胞、MM6细胞
MDA-MB157细胞类似产品::hUC-MSC细胞、CZ-1细胞、SUM-102细胞
Sun Yat-sen university Ophtalmic center-Retinoblastoma 50细胞类似产品::Hs822T细胞、SNU-449细胞、U266 B1细胞
CTX TNA2细胞类似产品::JB-6 Cl 30细胞、USMC细胞、C-32细胞
SHP-77 Cells(赠送Str鉴定报告)|人肺癌细胞
细胞物种来源:人源或鼠源等其它物种来源
[细胞产品包装]鲜活细胞:T25培养瓶(一瓶)或冻存细胞:1ml冻存管(两支)
悬浮细胞不容易转染:悬浮细胞是指细胞生长不依赖支持物表面,在培养液中呈悬浮状态生长,如淋巴细胞。在实验室经常会遇到悬浮细胞的转染,其和贴壁细胞转染还是有很大不同的。目前大多数实验室用的是脂质体类的转染试剂,脂质体转染是基于电荷吸引原理,先形成脂质体-DNA复合物,散布在细胞周围,然后通过细胞的内吞作用,将目的基因导入细胞内,而脂质体复合物与贴壁细胞的接触机会比悬浮细胞GAO出很多倍,所以,脂质体转染时悬浮细胞的转染效率要明显低于贴壁细胞。其次,脂质体试剂的毒性较大,这就使得悬浮细胞的转染更为困难了。另外,悬浮细胞不易培养,易死亡,也给细胞转染造成了一定的困难。为了提GAO悬浮细胞的转染效率,可以使用非脂质体的转染试剂,如纳米材料的。也可以使用电转染方法,针对悬浮细胞等难转染细胞还是挺不错的,电击对细胞有一定的损伤,ZuiHAO选用具有细胞膜修复功能的电转染试剂,可以将电击对细胞的伤害降到Zui低,悬浮细胞不易转染,选对试剂及良HAO的细胞培养环境才是关键。
细胞传代方法:3-4天换液1次。
MIA-PaCa-2细胞类似产品::Dakiki细胞、HSC3细胞、HCPEpiC细胞
C28/I2细胞类似产品::CHO/dhFr-细胞、Hos TE-85细胞、526 mel细胞
PLC8024细胞类似产品::LS-174T细胞、KYSE30细胞、Panc3_27细胞
JEG3细胞类似产品::L428细胞、CCRF-CEM C1细胞、HuO9细胞
CORL105细胞类似产品::HT-29细胞、Ontario Cancer Institute-Acute Myeloid Leukemia-3细胞、MDA-MB 361细胞
细胞来源说明:来源于RCB、ATCC、KCLB、DSMZ、ECACC、INCell、ScienCell、ECACC、JCRB、Asterand、ICLC等知名细胞库
SHP-77 Cells(赠送Str鉴定报告)|人肺癌细胞
细胞生长特性:悬浮生长,少量贴壁
4T1细胞类似产品::BSC40细胞、T173细胞、SK_HEP1细胞
LN-382细胞类似产品::W256细胞、SVGp12细胞、U-266细胞
COLO206F细胞类似产品::TC7细胞、INS1细胞、MonoMac6细胞
CFSC-2G细胞类似产品::H2405细胞、CCD-18Co细胞、NK 10a细胞
HT细胞类似产品::WM35细胞、MIHA细胞、SNU1细胞
IPLB-Sf21细胞类似产品::OV-2008细胞、HNTEC细胞、KYSE-510细胞
购买的细胞死亡或细胞存活率不佳可能原因?研究人员在细胞培养时出现存活率不佳,原因比较复杂,常见原因可归纳为:培养基使用错误或培养基品质不佳;血清使用错误或血清的品质不佳;解冻过程错误;冷冻细胞解冻后,加以洗涤细胞和离心;悬浑细胞误认为死细胞;培养温度使用错误;细胞置于-80℃太久等。建议严格参照ATCC的标准操作规程进行细胞复苏、冻存等工作。欲将一般动物细胞离心下来,其离心速率应为多少转速?欲回收动物细胞,其离心速率一般为300×g(约1OOOrpm),5-10分钟,转速过GAO或离心时间过长都将造成细胞死亡。合适的离心转速是根据相对离心力决定。RCF=1.119×105×r×(rpm)2,其中r为离心机转轴中心与离心套管底部内壁的距离;rpm为离心机每分钟的转数;RCF(relative centrifugal force)为相对离心力,以重力加速度g(980.66cm/s2)的倍数来表示单位。
细胞复苏后贴壁细胞较少的问题分析:总结1:复苏过程没有问题,是否是从液氮拿出直接放入温水,还有培养箱,二氧化碳浓度,培养基、PH值等环节。要么加GAO浓度FBS 15-20%,看看能否帮助贴壁,当然也需要考虑血清问题,还有确信拿来的细胞没问题。总结2:首先应该怀疑冻存,实际上复苏出问题的可能非常小,因为操作简单,而且死板。1、你冻存的时候是不是消化的时间过长,这是一般人所注意不到的,即使书上也不讲这个问题,太长的消化时间会让细胞复苏时失去贴壁能力,表现为先贴后死,原因是在你复苏的时候细胞已进入凋亡程序,不可逆转的死亡。2、你的冻存液HAO不HAO,是什么,甘油还是DMSO,质量非常重要,否则也会死亡。3、你的冻存液的量加的是不是太多,ATCC推荐是不超过7%,大于5%,太多也不HAO。4、你在冻存的时候是不是把DMSO混均匀,这个有一些影响,但不算太大。5、你的冻存是否按部就班,就是所温度梯度是不是把握严格,很多人容易忘却这个事情,因为这个东西流程长。6、如果你细胞污染,你是否能很快看到,我比我的导师能早一天看到污染。从这个角度讲建议去除离心这步。7、你的细胞在冻存前是否过密。还有,不赞成孵箱污染这个概念的,所有在一个孵箱里的细胞都污染一个细菌的话,这个细菌是源于孵箱的,但这不代表孵箱污染,因为孵箱无论你如何处理都有大量的细菌,问题在操作。每次污染的原因都要尽可能的找,以后就不犯同样的问题,这个很重要,不能靠猜,否则你就有可能细胞养绝Zui后换课题,这个见得太多了,别不当会事。
OVCAR10细胞类似产品::U 937细胞、LS-180细胞、SAOS 2细胞
LPC-H12细胞类似产品::SK-RC 42细胞、MCF7/WT细胞、Kuramochi细胞
TK+/- (clone 3.7.2C)细胞类似产品::NCI-H2106细胞、130 T细胞、PLC-8024细胞
NCI-H2591细胞类似产品::AML 12细胞、MC38细胞、Tu 212细胞
Michigan Cancer Foundation-7细胞类似产品::WM-239细胞、Hs 888Lu细胞、SW-13细胞
IMR-90细胞类似产品::LC1细胞、WILL2细胞、MIN6细胞
6-10B细胞类似产品::SK-ChA-1细胞、OVCA8细胞、SU-86-86细胞
SW 1116细胞类似产品::WM239A细胞、PF382细胞、MCF-12A细胞
OCI-Ly07细胞类似产品::MDA-175细胞、Nthy-ori 3-1细胞、U118MG细胞
NFS-60细胞类似产品::Hs-600-T细胞、MeSoTheliOma-211H细胞、293 H细胞
TE671/RD细胞类似产品::WB-F344细胞、NCIH345细胞、SNU739细胞
ChaGo K-1细胞类似产品::UCH1细胞、HIT clone T15细胞、KYSE 510细胞
Panc 4.03细胞类似产品::WEHI-3细胞、RTE细胞、NCI-H2452细胞
OCILY7细胞类似产品::SNU-520细胞、PT-67细胞、Hs839T细胞
SGC-996细胞类似产品::Hs 604.T细胞、HCET细胞、LAN1细胞
Hs888Lu细胞类似产品::COLO 829细胞、Y79细胞、SUM52PE细胞
Hs888Lu细胞类似产品::COLO 829细胞、Y79细胞、SUM52PE细胞
HepG2细胞类似产品::Centre Antoine Lacassagne-148细胞、Primary Liver Carcinoma/Poliomyelitis Research Foundation/5细胞、JKT1细胞
Colo741细胞类似产品::KYSE-410细胞、EnCa1细胞、TE671细胞
Human Melanoma Cell Bowes细胞类似产品::Jeko1细胞、hEM15A细胞、Ca 9-22细胞
CCRFCEM细胞类似产品::MM-1S细胞、SR786细胞、HTori:3细胞
SW-48细胞类似产品::COLO 16细胞、H-2030细胞、B16 F1细胞
OCI-Ly7细胞类似产品::NRK 49F细胞、HFT 8810细胞、PC-2 [Human pancreatic carcinoma]细胞
LA-N-6(OAN)细胞类似产品::Mel RM细胞、MHCC97H细胞、NG 108-15细胞
GAK细胞类似产品::RSC-364细胞、C-28I2细胞、SVEC4-10细胞
OV2008细胞类似产品::NS1-Ag4/1细胞、HRC-99细胞、NCI-H727细胞
RH7777细胞类似产品::KALS-1细胞、HCC-827细胞、NCI-128细胞
Merwin Plasma Cell tumor-11细胞类似产品::PAI细胞、SUM 190细胞、MCF12A细胞
801-D细胞类似产品::IPEC1细胞、Panc02细胞、PANC0813细胞
NPA细胞类似产品::Rabbit Kidney 13细胞、JB-6细胞、GM16136细胞
MIHA细胞类似产品::HCS-2/8细胞、NPC-039细胞、PaTu8988s细胞
AHH1细胞类似产品::GOTO细胞、DKMG细胞、NCI-HUT-596细胞
Ca 9-22细胞类似产品::Caco-2 BBe细胞、CHL细胞、CHP212细胞
MCA205细胞类似产品::JB-6细胞、COLO 320DM细胞、293c18细胞
RKO-AS-45-1细胞类似产品::SGC996细胞、SuDHL 5细胞、Vero 76 clone E6细胞
NPC-TW039细胞类似产品::Madison lung细胞、HCC-1954细胞、Ramos (RA)细胞
Clone Y-1细胞类似产品::C-Lu65细胞、H1666_DA细胞、CCLP1细胞
3-LL细胞类似产品::CCD 966 SK细胞、SRS-82细胞、SW-954细胞
Hs 895.T细胞类似产品::DMS 79细胞、SRA01/04细胞、HOP 92细胞
MCMEC细胞类似产品::IB-RS2细胞、HUT28细胞、PC-3/M细胞
MDAMB231细胞类似产品::MUTZ-1细胞、PANC-08-13细胞、H128细胞
SHP-77 Cells(赠送Str鉴定报告)|人肺癌细胞
C-Lu-65细胞类似产品::CMT-167细胞、AU565细胞、RH7777细胞
HLEB-3细胞类似产品::MM1细胞、Ramos-2G6-4C10细胞、U266B1细胞
SK MEL-28细胞类似产品::Mv 1 Lu细胞、SK-ChA1细胞、RGCs细胞
LLC-PK(1)细胞类似产品::Murine Leydig Tumor Cell line-1细胞、mRTEC细胞、HLMVEC细胞
TE 32细胞类似产品::Pro-5 Lec1.3c细胞、T-ALL 1细胞、NCI-H23细胞
TE 32细胞类似产品::Pro-5 Lec1.3c细胞、T-ALL 1细胞、NCI-H23细胞
COLO824细胞类似产品::U87MG细胞、G422细胞、H146细胞
U-CH1细胞类似产品::CAL33细胞、Rin-M-5F细胞、CT26WT细胞
Human Embryonic Skin细胞类似产品::BeWo细胞、UMUC3细胞、SUDHL1细胞
143B TK-细胞类似产品::GM03571细胞、MH-22a细胞、SK RC 52细胞
UPCI-SCC-90细胞类似产品::OCI AML4细胞、SU-DHL-10细胞、HCCC-9810细胞
H209细胞类似产品::HN6细胞、SKHEP1细胞、SPCA1细胞
Lewis lung carcinoma line 1细胞类似产品::MDA157细胞、IPEC-1细胞、SNU119细胞
MJ细胞类似产品::RN细胞、NCI-SNU-119细胞、Jurkat-FHCRC细胞
MJ细胞类似产品::RN细胞、NCI-SNU-119细胞、Jurkat-FHCRC细胞
Capan-1细胞类似产品::COLO-1细胞、SNU-520细胞、RPMI1846细胞
CCFSTTG1细胞类似产品::CORL105细胞、HSAEC1-KT细胞、HCC2279细胞
P3-X63-Ag8-653细胞类似产品::H250细胞、JKT1细胞、SJSA细胞
DU 145细胞类似产品::Fetal Human Lens-124细胞、McA-RH 8994细胞、U118-MG细胞
ACC-2细胞类似产品::NCIH226细胞、U373 MG细胞、Pt K1 (NBL-3)细胞
NCIH596细胞类似产品::Tu-212细胞、NCIH2066细胞、CL1细胞
NCI-HUT-292细胞类似产品::NCIH2291细胞、H322T细胞、SUDHL4细胞
HCT-15细胞类似产品::HEK293E细胞、J-82细胞、U373 MG细胞
SMMC 7721细胞类似产品::EBNA293细胞、NCIH1792细胞、H2347细胞
J.E6-1细胞类似产品::JROECL 33细胞、SU86_86细胞、18G3.cl 1细胞
LC-1细胞类似产品::NCI-H1836细胞、JB6 clone 30, subclone 7b细胞、CO115细胞
DoTc2 4510细胞类似产品::COLO201细胞、SACC-83细胞、T-47-D细胞
DLM8细胞类似产品::TFH细胞、U-343细胞、CC-LP-1细胞
Lec1细胞类似产品::ChaGo-K-1细胞、Caco-2/BBe 1细胞、EOMA细胞
H-209细胞类似产品::253J-BV细胞、UCLA RO-81A-1细胞、KS-1 [Human glioblastoma]细胞
Molm 13细胞类似产品::NTERA2-cloneD1细胞、PNT1/A细胞、SK-NSH细胞
U-343细胞类似产品::P3HR1-BL细胞、HCCC9810细胞、786-0细胞
GM01232细胞类似产品::Tu212细胞、32D.3细胞、J82 COT细胞
A-172 MG细胞类似产品::HCC-827细胞、COLO-824细胞、MEC1细胞
16HBE140细胞类似产品::NCI-SNU-475细胞、LCLC-103H细胞、BTI-TN5B1-4细胞
MCF10A细胞类似产品::NCI-H647细胞、GP5d细胞、CV-1.K细胞
WM-451Lu细胞类似产品::MD Anderson-Metastatic Breast-453细胞、H-1666细胞、LN-18细胞
NCIADRRES细胞类似产品::RWPE-1细胞、CEL细胞、Mesothelial cells transfected with pRSV-T 5A细胞
SGC996细胞类似产品::HEI-193细胞、HDF-a细胞、SNU-407细胞
DR2R1610细胞类似产品::253J细胞、50.B1细胞、Tregs细胞
L-M(TK-)细胞类似产品::GB-1细胞、BALB/3T3细胞、KMM1细胞
KM H-2细胞类似产品::NCI-H1838细胞、Kit 225细胞、AZ521细胞
SUP T1细胞类似产品::BT-325细胞、MT-2细胞、SKNF1细胞
HIT.T15细胞类似产品::M3 Clone M-3细胞、H7721细胞、Capan 1细胞
D283细胞类似产品::SKMEL3细胞、Intestinal Epithelioid Cell line No. 18细胞、Det 562细胞
Acanthosis Nigricans 3rd attempt-CArcinoma细胞类似产品::U251细胞、SNU1040细胞、MLFC细胞
NCIH226细胞类似产品::H-524细胞、LTPA细胞、COLO320DM细胞
H4-II-EC3细胞类似产品::SUM-190细胞、SKRC-20细胞、T241细胞
NL20SV细胞类似产品::MA-c细胞、NCI-SNU-398细胞、Jiyoye细胞
OSC19细胞类似产品::BL-6细胞、SEG-1细胞、SU86_86细胞
MC 116细胞类似产品::GM06141细胞、KFB细胞、MH-S细胞
HuPT3细胞类似产品::LU165细胞、624-mel细胞、COLO-738细胞
GA-10细胞类似产品::NIH3T3-L1细胞、HIEC-6细胞、K1细胞
MKN7细胞类似产品::Panc 1细胞、HS-445细胞、WM266mel细胞
LS174T细胞类似产品::Rat Lung-65细胞、Ra #1细胞、P3/X63/Ag8细胞
PLA801-95C细胞类似产品::NCI-HUT-292细胞、SK Mel 1细胞、H841细胞
2008细胞类似产品::T241细胞、1301细胞、SK-Col-1细胞
NCI-SNU-216细胞类似产品::KPL4细胞、ANA-1细胞、H4-II-EC3细胞
GM04680细胞类似产品::PL11细胞、KYSE270细胞、WSU-HN13细胞
SuDHL 10细胞类似产品::Madin-Darby Canine Kidney细胞、CATHa细胞、SK-MEL 28细胞
HEK-293细胞类似产品::Ramos 2G6.4C10细胞、OCI-Ly19细胞、NPA'87细胞
MGHU1细胞类似产品::WM2664细胞、MDA-MB-415细胞、RC-K8细胞
Granta 519细胞类似产品::HET-1A细胞、J 774A.1细胞、Central Adrenergic TH-expressing a细胞
Y3M细胞类似产品::HCCLM3细胞、DiFi细胞、DHL8细胞
Centre Antoine Lacassagne-62细胞类似产品::MESSA细胞、IHC-ST1细胞、CEM-CCRF (CAMR)细胞
CCD1112Sk细胞类似产品::NB1RGB细胞、BL6细胞、MV-4:11细胞
PANC0327细胞类似产品::3T3 L1细胞、EU-2细胞、Granta-519细胞
RT-BM 1细胞类似产品::B95.8细胞、SK MEL-28细胞、CemT4细胞
MHCC-97细胞类似产品::U-343细胞、LL2细胞、PTK-1细胞
SK.MEL.5细胞类似产品::Co 115细胞、HCT.116细胞、PLA801C细胞
KYSE 270细胞类似产品::HOP92细胞、Hs739T细胞、G-361细胞
WM266细胞类似产品::KE-39细胞、NTERA2-cloneD1细胞、293EBNA细胞
b.End3细胞类似产品::Calu 6细胞、C1498细胞、8305-C细胞
MSTO-211 H细胞类似产品::H-1666细胞、L5178Y-R细胞、Intestinal Porcine Epithelial Cell line-J2细胞
P3X63 Ag8.653细胞类似产品::Factor Dependent Cell-Paterson 1细胞、HHL-5细胞、MDA231-LM2-4175细胞
BaF3细胞类似产品::ECV304细胞、NCIH526细胞、H-1437细胞
HDLM2细胞类似产品::HT-115细胞、HIC细胞、Duke University 4475细胞
P3-NS1/1Ag 4.1细胞类似产品::SIRC细胞、VERO C 1008细胞、H-2122细胞
Pa14C细胞类似产品::DLD 1细胞、HL7702细胞、RPMI no. 8226细胞
HS940细胞类似产品::Panc_02_03细胞、Anip-973细胞、A-9细胞
PASMCS细胞类似产品::138MG细胞、P3 88 D1细胞、DLD1细胞
A-673细胞类似产品::NCI-H2085细胞、Biopsy xenograft of Pancreatic Carcinoma line-3细胞、KG-1a细胞
Leghorn Male Hepatoma cell line细胞类似产品::2V6.11细胞、P-19细胞、COR-L 105细胞
SK Mel28细胞类似产品::USMC细胞、KU 812F细胞、RWPE-2细胞
HEI-193细胞类似产品::HNSC细胞、NIH:OVCAR-5细胞、NCI-H1819细胞
JM-Jurkat细胞类似产品::PFSK-1细胞、TE85细胞、Hs274T细胞
TK10细胞类似产品::KY70细胞、SK HEP-1细胞、NCI-H1651细胞
NCI-H146细胞类似产品::B16-F10细胞、HCC1143细胞、DLD-1细胞
ABC-1细胞类似产品::NCIH1869细胞、L 363细胞、NCIH1930细胞
U20S细胞类似产品::GP-293细胞、HNE-1细胞、GA-10(Clone 4)细胞
RT4-D6-P2T细胞类似产品::CAKI.1细胞、H-2196细胞、AR-42J细胞
HCC-2108细胞类似产品::Human Embryonic Skin细胞、N-9细胞、KYSE-520细胞
B95-8细胞类似产品::TE 32.T细胞、CoC1细胞、118MG细胞
RS4:11细胞类似产品::PC-3/M细胞、Ramos (RA 1)细胞、COLO-394细胞
PAN 02细胞类似产品::MFM-223细胞、MTEC1细胞、RAW-264.7细胞
mRMEC细胞类似产品::A375mel细胞、SCL-II细胞、SK-GT-2细胞
MRC-9细胞类似产品::NCIH1155细胞、Hep-3B细胞、SNU-C2A细胞
P3JHR-1细胞类似产品::SV40-MES13细胞、NCI-H920细胞、SKNBE细胞
130T细胞类似产品::L 132细胞、HuPT4细胞、F81细胞
NUGC3细胞类似产品::VMRC-RCZ细胞、SU-DHL6细胞、16-HBEo细胞
OCI-Ly18细胞类似产品::HCC9724细胞、C-643细胞、LoVo细胞
NCIH1694细胞类似产品::GC1-SPG细胞、S3-HeLa细胞、Hs 636 T细胞
SO-RB50细胞类似产品::U118-MG细胞、NP69SV40T细胞、H-660细胞
4T1细胞类似产品::BSC40细胞、8402细胞、Giant Cell Tumor细胞
GM01232E细胞类似产品::P3.times.63 Ag8.653细胞、FL-83B细胞、NCTC-929细胞
Ca 9-22细胞类似产品::Caco-2 BBe细胞、EOL1细胞、KMH-2细胞
AHH-1细胞类似产品::H-1944细胞、HPAF-II细胞、H-510A细胞
DHL10细胞类似产品::H1793细胞、TB-1 Lu细胞、32D CL3细胞
C41细胞类似产品::HEK293-A细胞、C2A细胞、EMT6细胞
H-1092细胞类似产品::Hs 863.T细胞、MCF 10A细胞、H-1238细胞
MCA-38细胞类似产品::MILE SVEN 1细胞、MOLT 3细胞、OCI Ly10细胞
MAntle cell VERona-1细胞类似产品::CORL88细胞、PASMCS细胞、Tu686细胞
L-428细胞类似产品::NBLS细胞、SKGIIIA细胞、SNU-638细胞
Transformed C3H Mouse Kidney-1细胞类似产品::SW-1088细胞、NK92-MI细胞、HAEC细胞
PC3细胞类似产品::MDCK-2细胞、NCI-H1770细胞、NUGC3细胞
NCM356细胞类似产品::MDCK II细胞、REC1细胞、AK细胞
Panc_05_04细胞类似产品::JIMT1细胞、H2172细胞、McARH7777细胞
C2BBe1细胞类似产品::PC3-M细胞、GT39细胞、HPAF2细胞
REC1细胞类似产品::MKN-7细胞、HEMCSS细胞、CEM clone 7细胞
SHP-77 Cells(赠送Str鉴定报告)|人肺癌细胞
Mv.1.Lu细胞类似产品::YAC细胞、BC-027细胞、LICCF细胞
P-19细胞类似产品::HPAF/CD18细胞、184A1细胞、Spodoptera frugiperda clone 9细胞
TE9细胞类似产品::GM03569细胞、NCIH838细胞、RPMI-6666细胞
Hi-five细胞类似产品::HTh-74细胞、CAL851细胞、NCIH211细胞
PLC/PRF/5细胞类似产品::Ramos.G6.C10细胞、HEY A8细胞、OS-RC-2细胞
Scott and White No. 13细胞类似产品::NCI-H735细胞、MCF-7ADR细胞、NCIH740细胞
KMBC细胞类似产品::MKN-28细胞、TE 85 ClF-5细胞、Neukoplast细胞
Colon-38细胞类似产品::CEM/0细胞、786-0WT细胞、LTEP-s细胞
SW1116细胞类似产品::KYSE0520细胞、HT-1197细胞、NCI-H719细胞
COLO 679细胞类似产品::CAOV4细胞、BHK 21细胞、NCIH2066细胞
D-283 Med细胞类似产品::KALS1细胞、HCC1954 BL细胞、RA-FLSs细胞
Hk-2细胞类似产品::B5537SKIN细胞、BT20细胞、PC-10细胞
CCD-19Lu细胞类似产品::HTh74细胞、Pt K1 (NBL-3)细胞、H358细胞
A-875细胞类似产品::OVCA-433细胞、Helacyton gartleri细胞、MIA Paca2细胞
H-1404细胞类似产品::RPMI.8226细胞、CCC-HSF-1细胞、HTR-8细胞
SU8686细胞类似产品::BRL3A细胞、PANC-28细胞、LuCL4细胞
CACO2细胞类似产品::PCI:SG231细胞、HFB细胞、GBCSD细胞
H-1993细胞类似产品::Panc02细胞、Wistar Institute, Susan Hayflick细胞、293A细胞
Y3-Ag1,2,3细胞类似产品::HO-8910细胞、CD18/HPAF细胞、LLC-MK2细胞
P31FUJ细胞类似产品::DHL-16细胞、ME1细胞、FU-OV-1细胞
NSC-34细胞类似产品::CMK细胞、FRhK-4细胞、SKRC 39细胞
WERI-Rb-1细胞类似产品::HDLM-2细胞、RT112细胞、UM-UC-1细胞
Neuro 2a细胞类似产品::A10细胞、HCC-95细胞、OLN 93细胞
LS180细胞类似产品::SW982细胞、MDA-MB453细胞、Hs 294T细胞
C3H10T1/2 clone8细胞类似产品::COS-1细胞、MCF10A细胞、NCIH322细胞
Eca-109细胞类似产品::SKMEL1细胞、F-36P细胞、HCMEC(BL12-H)细胞
UO-31细胞类似产品::Human Kidney-2细胞、PC2细胞、MC-3T3细胞
NK62a细胞类似产品::OV-1063细胞、ZYM-SVEC01细胞、PG-LH7细胞
HRIF细胞类似产品::CV-1细胞、SUM149细胞、HPAF-II细胞
NCIH2030细胞类似产品::DoHH-2细胞、Metastatic Variant 522细胞、SNU387细胞
TK+/- (clone 3.7.2C)细胞类似产品::NCI-H2106细胞、MGECs细胞、PT-K75细胞
B5537SKIN细胞类似产品::NCI-H1092细胞、OV2008细胞、Hep-G2/C3A细胞
"